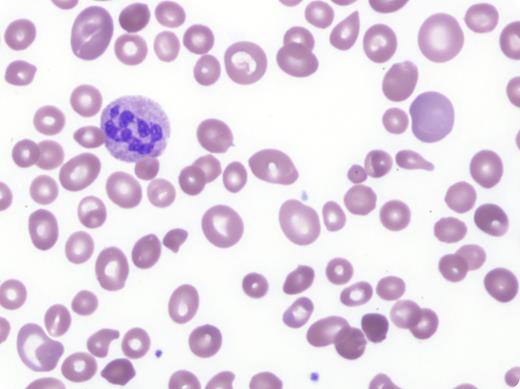
A previously healthy 43-year-old man with chronic alcoholism presented to a rural medical center with a 2-week history of confusion, fever, dyspnea, dizziness, and fatigue associated with diarrhea and hematochezia. Laboratory results were notable for a platelet count of 19 × 109/L, hemoglobin of 5.0 g/dL, hematocrit of 15.1%, white blood cell count of 3.2 × 109/L, a reticulocyte count of 5.9%, mean corpuscular volume of 118 fL, and normal creatinine. A peripheral blood smear was interpreted at the outside facility as having marked schistocytes. A diagnosis of presumed thrombotic thrombocytopenic purpura/hemolytic uremic syndrome was given. The patient was transfused with 3 units of plasma and transferred to a tertiary care hospital for therapeutic plasma exchange. A repeat peripheral blood smear showed a macrocytic anemia with increased anisopoikilocytosis, hypersegmented neutrophils, and marked thrombocytopenia consistent with megaloblastic anemia (see figure). Further testing revealed a decreased vitamin B12 level of 93 pg/mL with unremarkable iron studies. Although the patient’s profound thrombocytopenia was concerning, ADAMTS13 activity was measured at 71%, excluding thrombotic thrombocytopenic purpura. Additional workup was positive for intrinsic factor antibodies, confirming the diagnosis of pernicious anemia. / Although the clinical presentation and degree of thrombocytopenia may be concerning for a microangiopathic process, careful review of the peripheral blood will help direct appropriate clinical management. Severe megaloblastic anemia may cause marked anisopoikilocytosis with bizarre microcytes and thrombocytopenia. These findings should not be confused with microangiopathic hemolytic anemia.

A previously healthy 43-year-old man with chronic alcoholism presented to a rural medical center with a 2-week history of confusion, fever, dyspnea, dizziness, and fatigue associated with diarrhea and hematochezia. Laboratory results were notable for a platelet count of 19 × 109/L, hemoglobin of 5.0 g/dL, hematocrit of 15.1%, white blood cell count of 3.2 × 109/L, a reticulocyte count of 5.9%, mean corpuscular volume of 118 fL, and normal creatinine. A peripheral blood smear was interpreted at the outside facility as having marked schistocytes. A diagnosis of presumed thrombotic thrombocytopenic purpura/hemolytic uremic syndrome was given. The patient was transfused with 3 units of plasma and transferred to a tertiary care hospital for therapeutic plasma exchange. A repeat peripheral blood smear showed a macrocytic anemia with increased anisopoikilocytosis, hypersegmented neutrophils, and marked thrombocytopenia consistent with megaloblastic anemia (see figure). Further testing revealed a decreased vitamin B12 level of 93 pg/mL with unremarkable iron studies. Although the patient’s profound thrombocytopenia was concerning, ADAMTS13 activity was measured at 71%, excluding thrombotic thrombocytopenic purpura. Additional workup was positive for intrinsic factor antibodies, confirming the diagnosis of pernicious anemia.
Although the clinical presentation and degree of thrombocytopenia may be concerning for a microangiopathic process, careful review of the peripheral blood will help direct appropriate clinical management. Severe megaloblastic anemia may cause marked anisopoikilocytosis with bizarre microcytes and thrombocytopenia. These findings should not be confused with microangiopathic hemolytic anemia.
A previously healthy 43-year-old man with chronic alcoholism presented to a rural medical center with a 2-week history of confusion, fever, dyspnea, dizziness, and fatigue associated with diarrhea and hematochezia. Laboratory results were notable for a platelet count of 19 × 109/L, hemoglobin of 5.0 g/dL, hematocrit of 15.1%, white blood cell count of 3.2 × 109/L, a reticulocyte count of 5.9%, mean corpuscular volume of 118 fL, and normal creatinine. A peripheral blood smear was interpreted at the outside facility as having marked schistocytes. A diagnosis of presumed thrombotic thrombocytopenic purpura/hemolytic uremic syndrome was given. The patient was transfused with 3 units of plasma and transferred to a tertiary care hospital for therapeutic plasma exchange. A repeat peripheral blood smear showed a macrocytic anemia with increased anisopoikilocytosis, hypersegmented neutrophils, and marked thrombocytopenia consistent with megaloblastic anemia (see figure). Further testing revealed a decreased vitamin B12 level of 93 pg/mL with unremarkable iron studies. Although the patient’s profound thrombocytopenia was concerning, ADAMTS13 activity was measured at 71%, excluding thrombotic thrombocytopenic purpura. Additional workup was positive for intrinsic factor antibodies, confirming the diagnosis of pernicious anemia.
Although the clinical presentation and degree of thrombocytopenia may be concerning for a microangiopathic process, careful review of the peripheral blood will help direct appropriate clinical management. Severe megaloblastic anemia may cause marked anisopoikilocytosis with bizarre microcytes and thrombocytopenia. These findings should not be confused with microangiopathic hemolytic anemia.
For additional images, visit the ASH IMAGE BANK, a reference and teaching tool that is continually updated with new atlas and case study images. For more information visit http://imagebank.hematology.org.
This feature is available to Subscribers Only
Sign In or Create an Account Close Modal